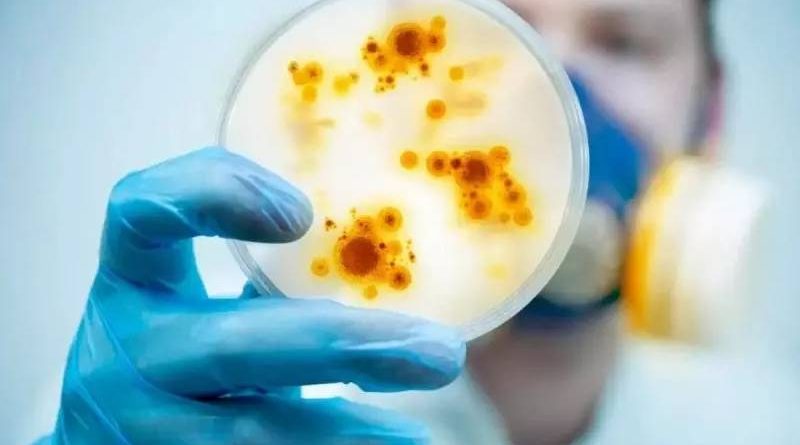

Vírus comedor de ânus mata em 30% dos casos e alerta Japão
Ação desse vírus muitas vezes é rápida e fulminante, atuando na garganta, pele, ânus e órgãos genitais. Autoridades ainda não sabem como atuar
Uma situação inusitada vem alarmando autoridades do Japão. O chamado “vírus comedor de ânus” vem se espalhando pelo país, chegando a causar alerta. A doença causada por ele é também chamada síndrome do choque tóxico estreptocócico (STSS).
Esse “apelido” dado ao vírus se deve à sua forma de agir, pois ele atua se proliferando na garganta, pele, ânus e órgãos genitais. A taxa de mortalidade dos infectados chega a 30%, o que é o motivo de tanta preocupação.
Nos dois primeiros meses de 2024 foram registrados 941 casos, o que deve ultrapassar os anos anteriores. Os sintomas causados pelo vírus vão desde febre e dificuldade respiratória a disfunção renal e hepática. Também causa pressão confusão mental, baixa pressão arterial, dores musculares e até vômitos.
 Doença mata aproximadamente 30% dos infectados – Foto: Reprodução
Doença mata aproximadamente 30% dos infectados – Foto: Reprodução
Vírus misterioso
É mais comum que ataque idosos, a partir dos 65 anos. Entretanto, novos casos com pacientes com menos de 50 anos têm deixado as autoridades alarmadas. No pior registro, um adolescente de 14 teve que amputar as mãos e os pés em razão do choque tóxico causado pelo vírus.
 Autoridade de saúde do Japão ainda não sabem como combater a ação do vírus – Foto: Reprodução
Autoridade de saúde do Japão ainda não sabem como combater a ação do vírus – Foto: Reprodução
“Há muita coisa que não sabemos sobre a atuação do vírus. Sobretudo essa forma fulminante de ataque, graves e repentinas do estreptococos. Também não temos ainda condições de explicar”, publicou o Instituto Nacional de Doenças Infecciosas (NIID) em comunicado recente.
Fonte:https://ndmais.com.br/REDAÇÃO ND,FLORIANÓPOLIS